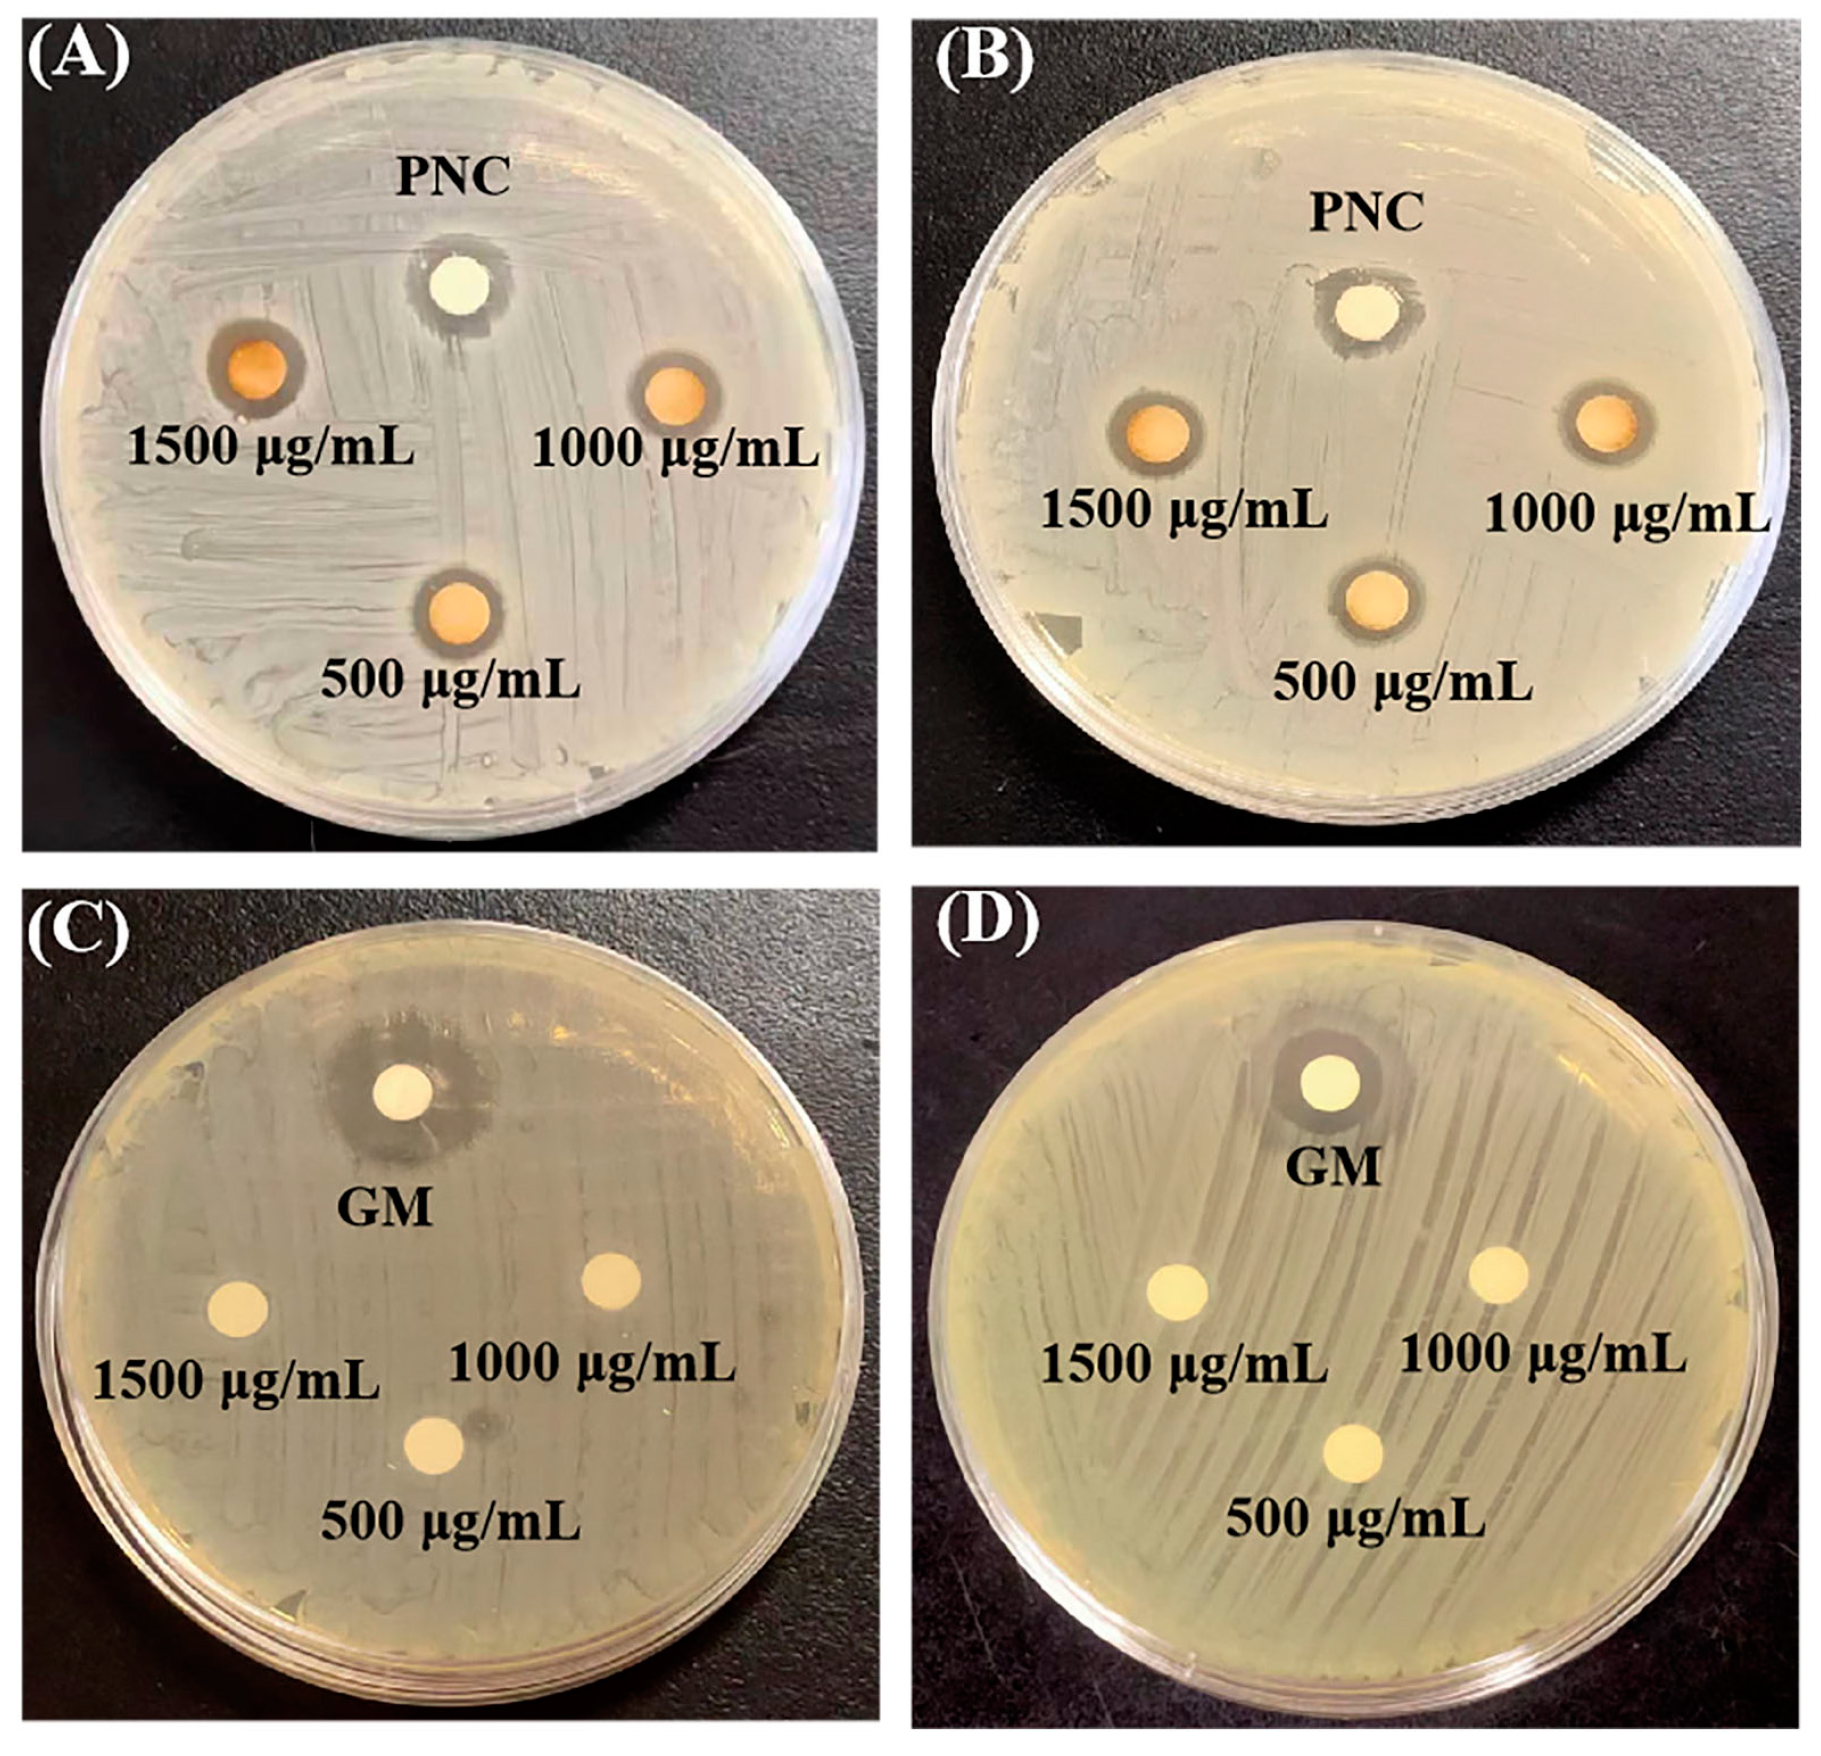
Molecules 29 05682 g006
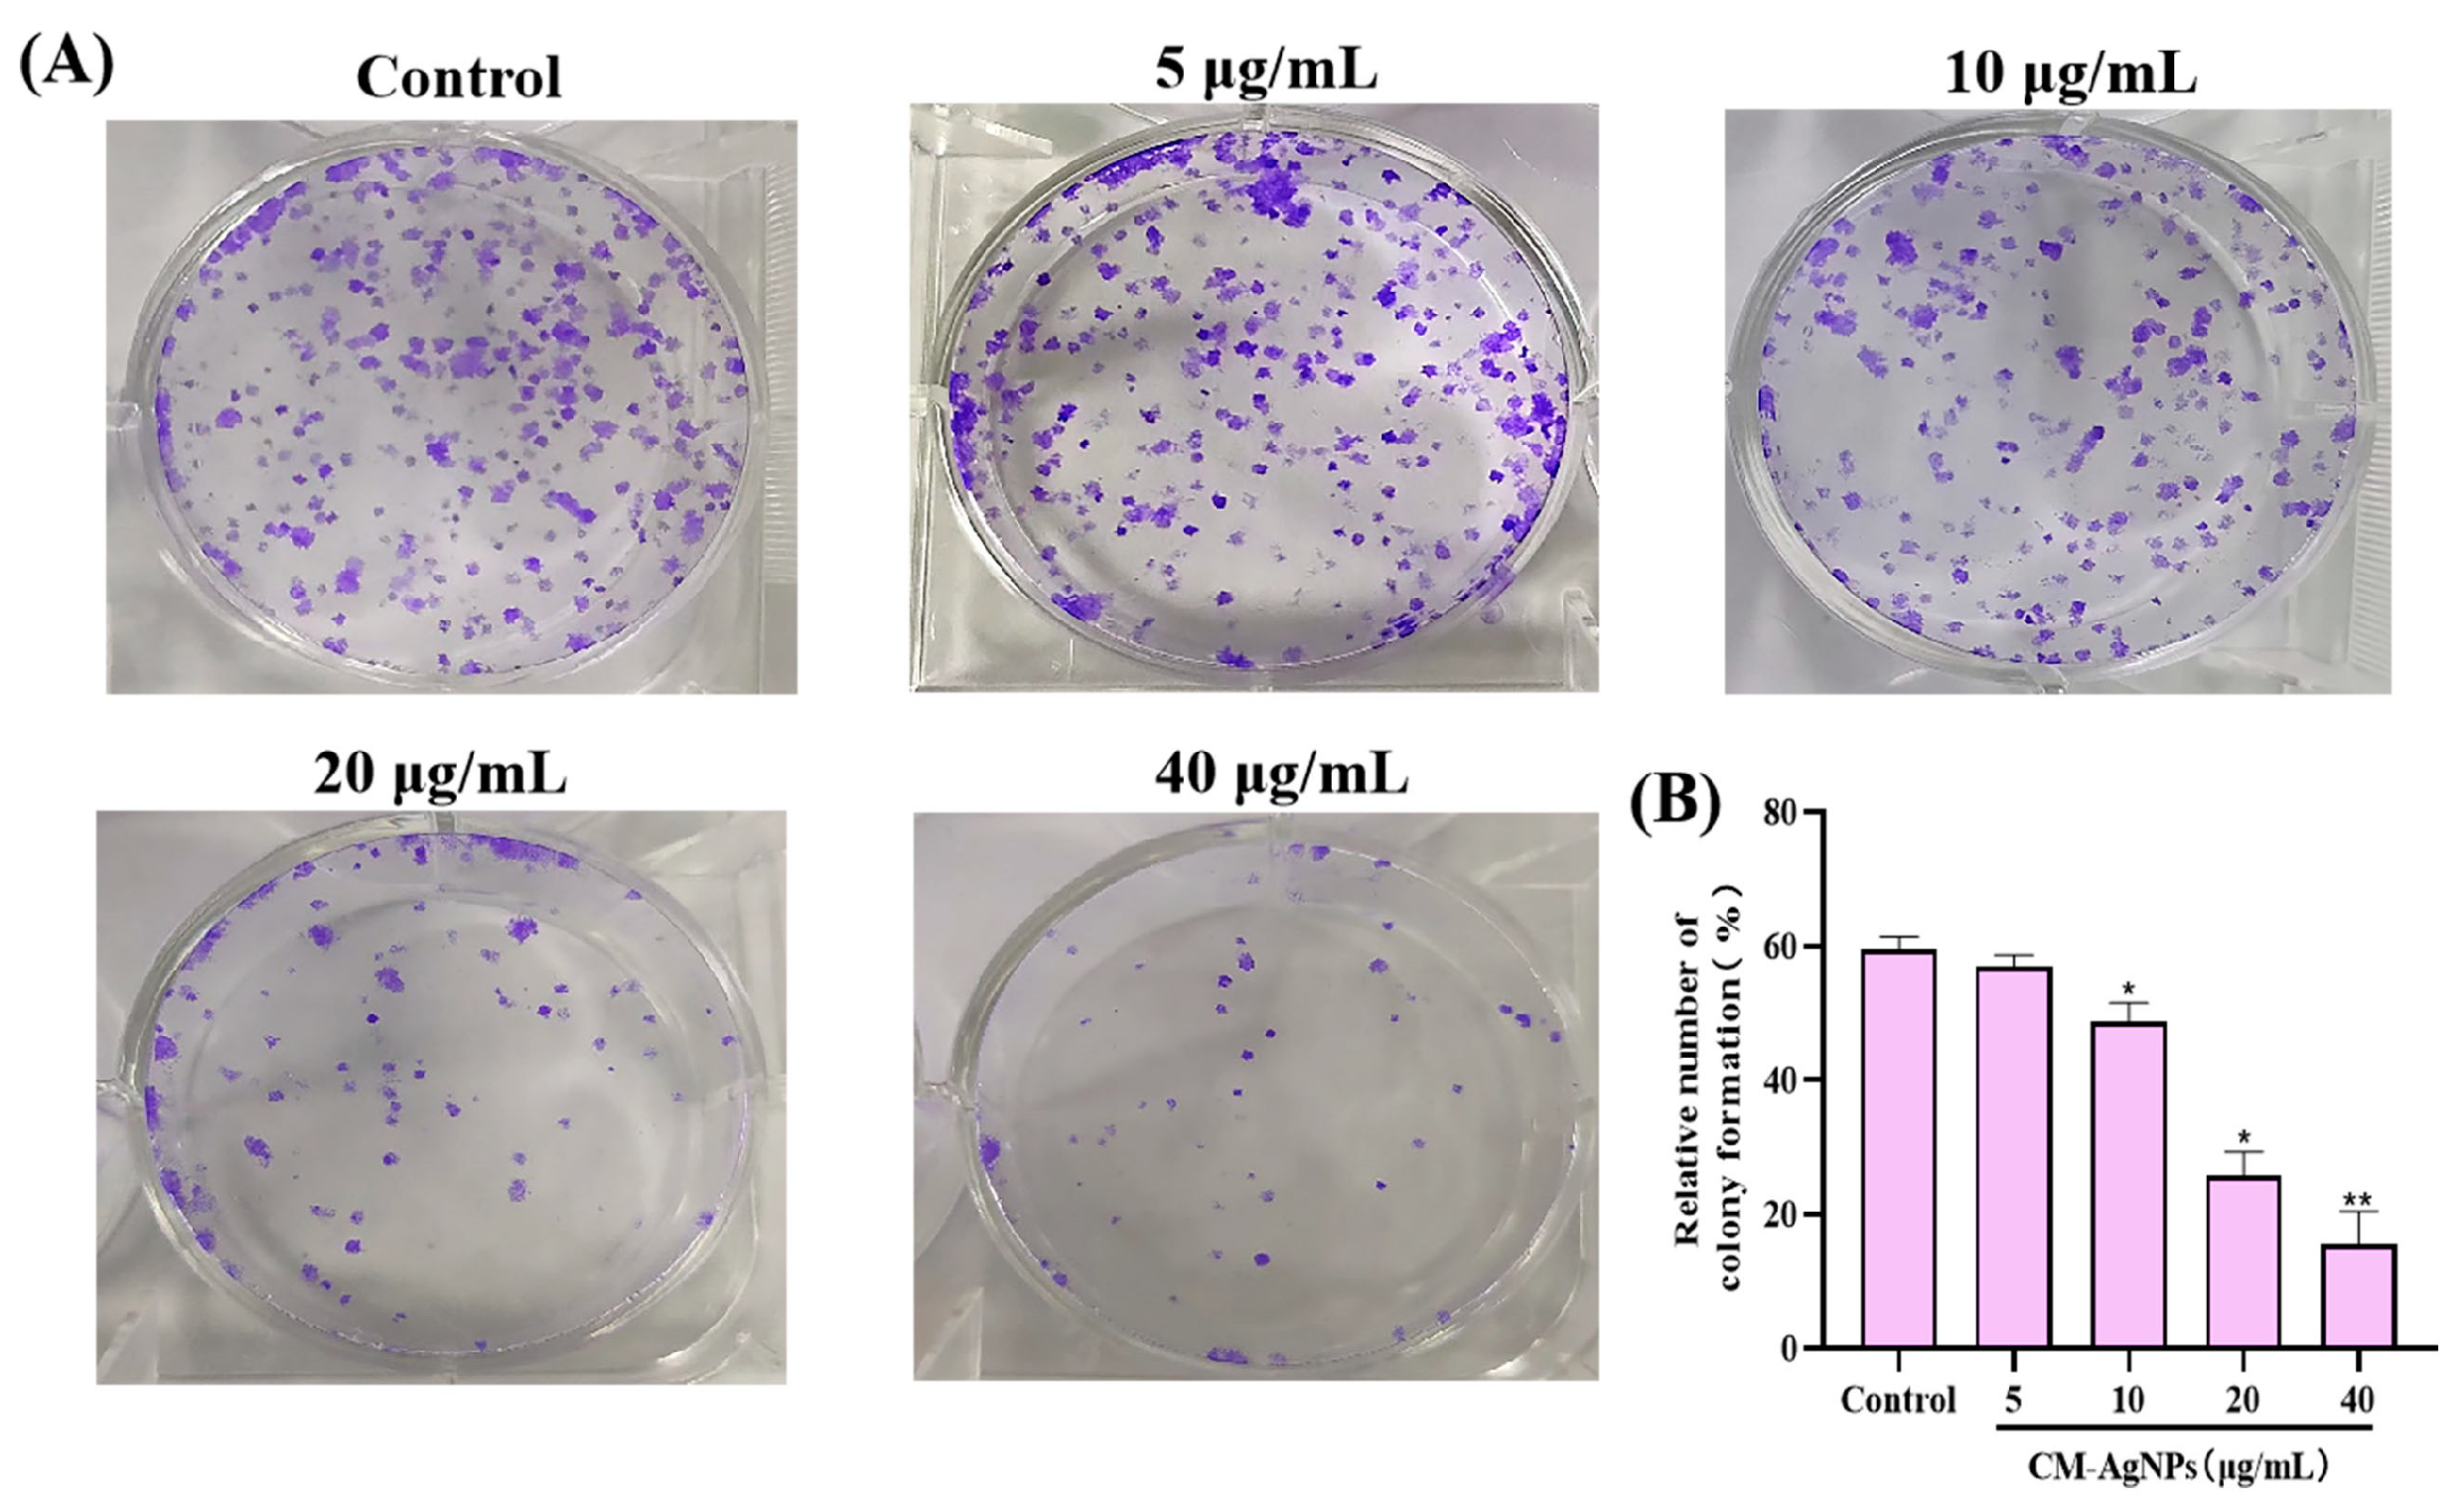
Molecules 29 05682 g009

Green Synthesis of Silver Nanoparticles (CM-AgNPs) from the Root of Chuanminshen for Improving the Cytotoxicity Effect in Cancer Cells with Antibacterial and Antioxidant Activities
Abstract
1. Introduction
2. Results
2.1. High-Performance Liquid Chromatography-Mass Spectrometry (HPLC-MS) Analysis of Chuanminshen Extract
2.2. Optimization Condition Analysis of CM-AgNPs
2.3. Characterization of CM-AgNPs
2.4. Stability Analysis
2.5. Antioxidant Activity of CM-AgNPs
2.6. Antimicrobial Activity of CM-AgNPs
2.7. In Vitro Inhibitory Proliferative and Inducing Apoptosis Activity of CM-AgNPs in HCT116
2.7.1. Cytotoxicity Evaluation of CM-AgNPs in Various Cells
2.7.2. Clone Formation Assay Analysis
2.7.3. Hoechst Stain Assay Analysis
2.7.4. Apoptosis Analysis
2.7.5. ROS Production Level Analysis
2.7.6. MMP Analysis
2.7.7. Western Blot Analysis
3. Discussion
4. Materials and Methods
4.1. Preparation of CM Root Extract
4.2. High-Performance Liquid Chromatography-Mass Spectrometry (HPLC-MS) Analysis
4.3. Synthesis of CM-AgNPs
4.4. Optimization of Preparation Conditions of CM-AgNPs
4.5. Characterization of CM-AgNPs
4.6. Stability Analysis of CM-AgNPs in Different Media
4.7. Antibacterial Assay of CM-AgNPs
4.8. The Minimum Inhibitory Concentration (MIC) and Minimum Bactericidal Concentration (MBC) Assay of CM-AgNPs
4.9. In Vitro DPPH Radical Scavenging Assay
4.10. In Vitro Inhibitory Proliferative and Inducing Apoptosis Activity of CM-AgNPs in HCT116
4.10.1. Cytotoxicity Evaluation of CM-AgNPs in Various Cells
4.10.2. Hoechst Staining Assay
4.10.3. Clone Formation Assay
4.10.4. Apoptosis Measurement
4.10.5. Detection of ROS Level
4.10.6. MMP Measurement
4.10.7. Western Blotting
4.10.8. Statistical Analysis
5. Conclusions
Supplementary Materials
Author Contributions
Funding
Institutional Review Board Statement
Informed Consent Statement
Data Availability Statement
Conflicts of Interest
References
- Habeeb Rahuman, H.B.; Dhandapani, R.; Narayanan, S.; Palanivel, V.; Paramasivam, R.; Subbarayalu, R.; Thangavelu, S.; Muthupandian, S. Medicinal plants mediated the green synthesis of silver nanoparticles and their biomedical applications. IET Nanobiotechnol. 2022, 16, 115–144. [Google Scholar] [CrossRef] [PubMed]
- Rather, M.A.; Agarwal, D.; Kumar, S.; Sundaray, J.K. Nanobiotechnology: Prospects and Applications in Aquaculture. In Advances in Fisheries Biotechnology; Springer: Berlin/Heidelberg, Germany, 2022; pp. 197–210. [Google Scholar]
- Keskin, M.; Kaya, G.; Bayram, S.; Kurek-Gorecka, A.; Olczyk, P. Green Synthesis, Characterization, Antioxidant, Antibacterial and Enzyme Inhibition Effects of Chestnut (Castanea sativa) Honey-Mediated Silver Nanoparticles. Molecules 2023, 28, 2762. [Google Scholar] [CrossRef] [PubMed]
- Paiva-Santos, A.C.; Herdade, A.M.; Guerra, C.; Peixoto, D.; Pereira-Silva, M.; Zeinali, M.; Mascarenhas-Melo, F.; Paranhos, A.; Veiga, F. Plant-mediated green synthesis of metal-based nanoparticles for dermopharmaceutical and cosmetic applications. Int. J. Pharm. 2021, 597, 120311. [Google Scholar] [CrossRef]
- Bharadwaj, K.K.; Rabha, B.; Pati, S.; Choudhury, B.K.; Sarkar, T.; Gogoi, S.K.; Kakati, N.; Baishya, D.; Kari, Z.A.; Edinur, H.A. Green synthesis of silver nanoparticles using Diospyros malabarica fruit extract and assessments of their antimicrobial, anticancer and catalytic reduction of 4-nitrophenol (4-NP). Nanomaterials 2021, 11, 1999. [Google Scholar] [CrossRef] [PubMed]
- Heinemann, M.G.; Rosa, C.H.; Rosa, G.R.; Dias, D. Biogenic synthesis of gold and silver nanoparticles used in environmental applications: A review. Microbe 2024, 30, e00129. [Google Scholar] [CrossRef]
- Ferdous, J.; Manun, A.A.; Rahman, M.M.; Rana, R.; Huda, N.; Huq, A.; Rashid, A.; Kabir, M.K.; Bari, A. Green Synthesis and Characterization of Silver Nanoparticles from Nigella sativa L. Seeds and It’s Against Human Pathogenic Bacteria and Fungi. Int. J. Anal. Exp. Modal Anal. 2021, 4, 100111. [Google Scholar] [CrossRef]
- Ghaffari-Moghaddam, M.; Hadi-Dabanlou, R.; Khajeh, M.; Rakhshanipour, M.; Shameli, K. Green synthesis of silver nanoparticles using plant extracts. Korean J. Chem. Eng. 2014, 31, 548–557. [Google Scholar] [CrossRef]
- Balkrishna, A.; Sharma, V.K.; Das, S.K.; Mishra, N.; Bisht, L.; Joshi, A.; Sharma, N. Characterization and anti-cancerous effect of Putranjiva roxburghii seed extract mediated silver nanoparticles on human colon (HCT-116), pancreatic (PANC-1) and breast (MDA-MB 231) cancer cell lines: A comparative study. Int. J. Nanomed. 2020, 15, 573–585. [Google Scholar] [CrossRef]
- Zorraquin-Pena, I.; Cueva, C.; Gonzalez de Llano, D.; Bartolome, B.; Moreno-Arribas, M.V. Glutathione-stabilized silver nanoparticles: Antibacterial activity against periodontal bacteria, and cytotoxicity and inflammatory response in oral cells. Biomedicines 2020, 8, 375. [Google Scholar] [CrossRef]
- Qin, S.; Tong, X.; Sun, L.; Zhou, S.; Liu, S.; Zheng, C.; Yu, H. The broad-spectrum antibacteria effects and mechanism of new-type silver nanoparticles in vitro. Zhongguo Weishengtaxixue Zazhi/Chin. J. Microecol. 2018, 30, 1024–1028. [Google Scholar]
- Lu, H.; Liu, S.; Zhang, Y. Development of novel green synthesized silver nanoparticles with superior antibacterial and wound healing properties in nursing care after rectal surgery. J. Inorg. Organomet. Polym. Mater. 2022, 32, 773–780. [Google Scholar] [CrossRef]
- Shao, J.; Wang, B.; Li, J.; Jansen, J.A.; Walboomers, X.F.; Yang, F. Antibacterial effect and wound healing ability of silver nanoparticles incorporation into chitosan-based nanofibrous membranes. Mater. Sci. Eng. C 2019, 98, 1053–1063. [Google Scholar] [CrossRef] [PubMed]
- Venkatachalam, P.; Sangeetha, P.; Geetha, N.; Sahi, S.V. Phytofabrication of bioactive molecules encapsulated metallic silver nanoparticles from Cucumis sativus L. and its enhanced wound healing potential in rat model. J. Nanomater. 2015, 16, 241. [Google Scholar] [CrossRef]
- Chandraker, S.K.; Lal, M.; Dhruve, P.; Yadav, A.K.; Singh, R.P.; Varma, R.S.; Shukla, R. Bioengineered and biocompatible silver nanoparticles from Thalictrum foliolosum DC and their biomedical applications. Clean. Technol. Environ. Policy 2022, 24, 2479–2494. [Google Scholar] [CrossRef]
- Naveed, M.; Bukhari, B.; Aziz, T.; Zaib, S.; Mansoor, M.A.; Khan, A.A.; Shahzad, M.; Dablool, A.S.; Alruways, M.W.; Almalki, A.A. Green synthesis of silver nanoparticles using the plant extract of Acer oblongifolium and study of its antibacterial and antiproliferative activity via mathematical approaches. Molecules 2022, 27, 4226. [Google Scholar] [CrossRef] [PubMed]
- Fernandez, C.C.; Sokolonski, A.R.; Fonseca, M.S.; Stanisic, D.; Araújo, D.B.; Azevedo, V.; Portela, R.D.; Tasic, L. Applications of Silver Nanoparticles in Dentistry: Advances and Technological Innovation. Int. J. Mol. Sci. 2021, 22, 2485. [Google Scholar] [CrossRef] [PubMed]
- Mishra, J.; Kour, A.; Amin, D.S.; Panda, J.J. Biofabricated smart-nanosilver: Promising armamentarium for cancer and pathogenic diseases. Colloids Interface Sci. Commun. 2021, 44, 100459. [Google Scholar] [CrossRef]
- Farshori, N.N.; Al-Oqail, M.M.; Al-Sheddi, E.S.; Al-Massarani, S.M.; Saquib, Q.; Siddiqui, M.A.; Wahab, R.; Al-Khedhairy, A.A. Green synthesis of silver nanoparticles using Phoenix dactylifera seed extract and its anticancer effect against human lung adenocarcinoma cells. J. Drug Deliv. Sci. Technol. 2022, 70, 103260. [Google Scholar] [CrossRef]
- Elumalai, M.; Nagaraj, G.; Kasthuri, J.; Vellaichamy, E.; Rajendiran, N. Evaluation of cytotoxic activity against A549 human lung cancer cells using green synthesized N-Cholyl D-Penicillamine encapsulated silver and gold nanoparticles. Inorg. Chem. Commun. 2023, 153, 110834. [Google Scholar] [CrossRef]
- Rana, A.; Pandey, S.; Matiyani, M.; Tiwari, H.; Negi, P.B.; Dokwal, S.; Sahoo, N.G. Pink photoluminescent nitrogen-doped graphene oxide nanosheets from Juniperus squamata roots and their cytotoxic potential against human cervical cancer cells (HeLa cells) and Plasmodium falciparum an agent of malaria: A green approach. Mater. Chem. Phys. 2023, 307, 128119. [Google Scholar] [CrossRef]
- Zhang, X.; Xiao, Y.; Huang, Q. The cellular uptake of Cordyceps sinensis exopolysaccharide-selenium nanoparticles and their induced apoptosis of HepG2 cells via mitochondria-and death receptor-mediated pathways. Int. J. Biol. Macromol. 2023, 247, 125747. [Google Scholar] [CrossRef] [PubMed]
- Alobaid, H.M.; Alzhrani, A.H.; Majrashi, N.A.; Alkhuriji, A.F.; Alajmi, R.A.; Yehia, H.M.; Awad, M.A.; Almurshedi, A.S.; Almnaizel, A.T.; Elkhadragy, M.F. Effect of biosynthesized silver nanoparticles by Garcinia mangostana extract against human breast cancer cell line MCF-7. Food Sci. Technol. 2022, 42, e41622. [Google Scholar] [CrossRef]
- Sanati, M.; Afshari, A.R.; Kesharwani, P.; Sukhorukov, V.N.; Sahebkar, A. Recent trends in the application of nanoparticles in cancer therapy: The involvement of oxidative stress. J. Control. Release 2022, 348, 287–304. [Google Scholar] [CrossRef] [PubMed]
- Takac, P.; Michalkova, R.; Cizmarikova, M.; Bedlovicova, Z.; Balazova, L.; Takacova, G. The Role of Silver Nanoparticles in the Diagnosis and Treatment of Cancer: Are There Any Perspectives for the Future? Life 2023, 13, 466. [Google Scholar] [CrossRef] [PubMed]
- Ahmad, H.S.; Ateeb, M.; Noreen, S.; Farooq, M.I.; Baig, M.M.F.A.; Nazar, M.S.; Akhtar, M.F.; Ahmad, K.; Ayub, A.R.; Shoukat, H. Biomimetic synthesis and characterization of silver nanoparticles from Dipterygium glaucum extract and its anti-cancerous activities. J. Mol. Struct. 2023, 1282, 135196. [Google Scholar] [CrossRef]
- Fayadh, S.M.; Mohammed, A.H. Silver nanoparticles induced apoptosis in papillary and follicular thyroid carcinoma cells. Phys. Med. 2022, 14, 100056. [Google Scholar] [CrossRef]
- Fan, J.; Feng, H.; Yu, Y.; Sun, M.; Liu, Y.; Li, T.; Sun, X.; Liu, S.; Sun, M. Antioxidant activities of the polysaccharides of Chuanminshen violaceum. Carbohydr. Polym. 2017, 157, 629–636. [Google Scholar] [CrossRef]
- He, P.; Zhang, M.; Zhao, M.; Zhang, M.; Ma, B.; Lv, H.; Han, Y.; Wu, D.; Zhong, Z.; Zhao, W. A novel polysaccharide from Chuanminshen violaceum and its protective effect against myocardial injury. Front. Nutr. 2022, 9, 961182. [Google Scholar] [CrossRef]
- Hashemitabar, G.; Aflakian, F.; Sabzevar, A.H. Assessment of antibacterial, antioxidant, and anticancer effects of biosynthesized silver nanoparticles using Teucrium polium extract. J. Mol. Struct. 2023, 1291, 136076. [Google Scholar] [CrossRef]
- Dridi, R.; Essghaier, B.; Hannachi, H.; Khedher, G.B.; Chaffei, C.; Zid, M.F. Biosynthesized silver nanoparticles using Anagallis monelli: Evaluation of antioxidant activity, antibacterial and antifungal effects. J. Mol. Struct. 2022, 1251, 132076. [Google Scholar] [CrossRef]
- Saxena, S.; Rao, P. GC-MS screening of bioactive constituents and antioxidant profiling in an invasive weed, Malva strum Coromandel anum (L.) Garcke. J. Pharma Innova 2018, 7, 738–746. [Google Scholar]
- Hu, X.; Wu, L.; Du, M.; Wang, L. Eco-friendly synthesis of size-controlled silver nanoparticles by using Areca catechu nut aqueous extract and investigation of their potent antioxidant and anti-bacterial activities. Arab. J. Chem. 2022, 15, 103763. [Google Scholar] [CrossRef]
- Waghchaure, R.H.; Adole, V.A. Biosynthesis of metal and metal oxide nanoparticles using various parts of plants for antibacterial, antifungal and anticancer activity: A review. J. Indian Chem. Soc. 2023, 100, 100987. [Google Scholar] [CrossRef]
- Yang, J.; Ju, P.; Dong, X.; Duan, J.; Xiao, H.; Tang, X.; Zhai, X.; Hou, B. Green synthesis of functional metallic nanoparticles by dissimilatory metal-reducing bacteria “Shewanella”: A comprehensive review. J. Mater. Sci. Technol. 2023, 158, 63–76. [Google Scholar] [CrossRef]
- Ibrahim, S.; Ahmad, Z.; Manzoor, M.Z.; Mujahid, M.; Faheem, Z.; Adnan, A. Optimization for biogenic microbial synthesis of silver nanoparticles through response surface methodology, characterization, their antimicrobial, antioxidant, and catalytic potential. Sci. Rep. 2021, 11, 770. [Google Scholar] [CrossRef] [PubMed]
- Nallappan, D.; Fauzi, A.N.; Krishna, B.S.; Kumar, B.P.; Reddy, A.V.K.; Syed, T.; Reddy, C.S.; Yaacob, N.S.; Rao, P.V. Green biosynthesis, antioxidant, antibacterial, and anticancer activities of silver nanoparticles of Luffa acutangula leaf extract. BioMed Res. Int. 2021, 2021, 5125681. [Google Scholar] [CrossRef]
- Zulfiqar, H.; Amjad, M.S.; Mehmood, A.; Mustafa, G.; Binish, Z.; Khan, S.; Arshad, H.; Prockow, J.; Perez de la Lastra, J.M. Antibacterial, antioxidant, and phytotoxic potential of Phytosynthesized silver nanoparticles using Elaeagnus umbellata fruit extract. Molecules 2022, 27, 5847. [Google Scholar] [CrossRef]
- Balciunaitiene, A.; Puzeryte, V.; Radenkovs, V.; Krasnova, I.; Memvanga, P.B.; Viskelis, P.; Streimikyte, P.; Viskelis, J. Sustainable–green synthesis of Silver nanoparticles using aqueous Hyssopus officinalis and Calendula officinalis extracts and their antioxidant and antibacterial activities. Molecules 2022, 27, 7700. [Google Scholar] [CrossRef]
- Yin, I.X.; Zhang, J.; Zhao, I.S.; Mei, M.L.; Li, Q.; Chu, C.H. The antibacterial mechanism of silver nanoparticles and its application in dentistry. Int. J. Nanomed. 2020, 15, 2555–2562. [Google Scholar] [CrossRef]
- Godoy-Gallardo, M.; Eckhard, U.; Delgado, L.M.; de Roo Puente, Y.J.; Hoyos-Nogués, M.; Gil, F.J.; Perez, R.A. Antibacterial approaches in tissue engineering using metal ions and nanoparticles: From mechanisms to applications. Bioact. Mater. 2021, 6, 4470–4490. [Google Scholar] [CrossRef]
- Arif, M.; Ullah, R.; Ahmad, M.; Ali, A.; Ullah, Z.; Ali, M.; Al-Joufi, F.A.; Zahoor, M.; Sher, H. Green synthesis of silver nanoparticles using Euphorbia wallichii leaf extract: Its antibacterial action against citrus canker causal agent and antioxidant potential. Molecules 2022, 27, 3525. [Google Scholar] [CrossRef] [PubMed]
- Abduladheem Jabbar, R.; Neima Hussien, N. Investigation of antioxidant and cytotoxicity effects of silver nanoparticles produced by biosynthesis using Lactobacillus gasseri. Arch. Razi Inst. 2021, 76, 781–793. [Google Scholar] [PubMed]
- Gecer, E.N.; Erenler, R.; Temiz, C.; Genc, N.; Yildiz, I. Green synthesis of silver nanoparticles from Echinacea purpurea (L.) Moench with antioxidant profile. Part. Sci. Technol. 2022, 40, 50–57. [Google Scholar]
- Sivakumar, J.; Suresh, S.; Zin, T.; US, M.R. Antidiabetic potential and high synergistic antibacterial activity of silver nanoparticles synthesised with Musa paradisiaca tepal extract. Med. J. Malays. 2021, 76, 80–86. [Google Scholar]
- Sumra, A.A.; Zain, M.; Saleem, T.; Yasin, G.; Azhar, M.F.; Zaman, Q.U.; Budhram-Mahadeo, V.; Ali, H.M. Biogenic Synthesis, Characterization, and In vitro Biological Evaluation of Silver Nanoparticles Using Cleome brachycarpa. Plants 2023, 12, 1578. [Google Scholar] [CrossRef] [PubMed]
- Hublikar, L.V.; Ganachari, S.V.; Patil, V.B.; Nandi, S.; Honnad, A. Anticancer potential of biologically synthesized silver nanoparticles using Lantana camara leaf extract. Prog. Biomater. 2023, 12, 155–169. [Google Scholar] [CrossRef]
- Motafeghi, F.; Gerami, M.; Mortazavi, P.; Khayambashi, B.; Ghassemi-Barghi, N.; Shokrzadeh, M.J. Green synthesis of silver nanoparticles, graphene, and silver-graphene nanocomposite using Melissa officinalis ethanolic extract: Anticancer effect on MCF-7 cell line. Iran. J. Basic Med. Sci. 2023, 26, 57. [Google Scholar]
- Pungle, R.; Nile, S.H.; Makwana, N.; Singh, R.; Singh, R.P.; Kharat, A.S. Green synthesis of silver nanoparticles using the Tridax procumbens plant extract and screening of its antimicrobial and anticancer activities. Oxidative Med. Cell. Longev. 2022, 2022, 9671594. [Google Scholar] [CrossRef]
- Gupta, P.; Rai, N.; Verma, A.; Saikia, D.; Singh, S.P.; Kumar, R.; Singh, S.K.; Kumar, D.; Gautam, V. Green-based approach to synthesize silver nanoparticles using the fungal endophyte Penicillium oxalicum and their antimicrobial, antioxidant, and in vitro anticancer potential. ACS Omega 2022, 7, 46653–46673. [Google Scholar] [CrossRef] [PubMed]
- Hashemi, Z.; Mizwari, Z.M.; Mohammadi-Aghdam, S.; Mortazavi-Derazkola, S.; Ebrahimzadeh, M.A. Sustainable green synthesis of silver nanoparticles using Sambucus ebulus phenolic extract (AgNPs@ SEE): Optimization and assessment of photocatalytic degradation of methyl orange and their in vitro antibacterial and anticancer activity. Arab. J. Chem. 2022, 15, 103525. [Google Scholar] [CrossRef]
- Wang, Y.; Qi, H.; Liu, Y.; Duan, C.; Liu, X.; Xia, T.; Chen, D.; Piao, H.-L.; Liu, H.-X.J.T. The double-edged roles of ROS in cancer prevention and therapy. Theranostics 2021, 11, 4839. [Google Scholar] [CrossRef] [PubMed]
- Maes, M.E.; Schlamp, C.L.; Nickells, R.W. BAX to basics: How the BCL2 gene family controls the death of retinal ganglion cells. Prog. Retin. Eye Res. 2017, 57, 1–25. [Google Scholar] [CrossRef] [PubMed]
- Morris, J.L.; Gillet, G.; Prudent, J.; Popgeorgiev, N. Bcl-2 family of proteins in the control of mitochondrial calcium signalling: An old chap with new roles. Int. J. Mol. Sci. 2021, 22, 3730. [Google Scholar] [CrossRef] [PubMed]
- Tang, Q.; Chen, H.; Mai, Z.; Sun, H.; Xu, L.; Wu, G.; Tu, Z.; Cheng, X.; Wang, X.; Chen, T. Bim-and Bax-mediated mitochondrial pathway dominates abivertinib-induced apoptosis and ferroptosis. Free Radic. Biol. Med. 2022, 180, 198–209. [Google Scholar] [CrossRef] [PubMed]
- Araya, L.E.; Soni, I.V.; Hardy, J.A.; Julien, O. Deorphanizing caspase-3 and caspase-9 substrates in and out of apoptosis with deep substrate profiling. ACS Chem. Biol. 2021, 16, 2280–2296. [Google Scholar] [CrossRef]
- Vogeler, S.; Carboni, S.; Li, X.; Joyce, A. Phylogenetic analysis of the caspase family in bivalves: Implications for programmed cell death, immune response and development. BMC Genom. 2021, 22, 80. [Google Scholar] [CrossRef]
- Augustin, I.; Dewi, D.L.; Hundshammer, J.; Rempel, E.; Brunk, F.; Boutros, M. Immune cell recruitment in teratomas is impaired by increased Wnt secretion. Stem Cell Res. 2016, 17, 607–615. [Google Scholar] [CrossRef]
- Mobaraki, F.; Momeni, M.; Jahromi, M.; Kasmaie, F.M.; Barghbani, M.; Yazdi, M.E.T.; Meshkat, Z.; Shandiz, F.H.; Hosseini, S.M. Apoptotic, antioxidant and cytotoxic properties of synthesized AgNPs using green tea against human testicular embryonic cancer stem cells. Process Biochem. 2022, 119, 106–118. [Google Scholar] [CrossRef]
- Aghabozorgi, A.S.; Ebrahimi, R.; Bahiraee, A.; Tehrani, S.S.; Nabizadeh, F.; Setayesh, L.; Jafarzadeh-Esfehani, R.; Ferns, G.A.; Avan, A.; Rashidi, Z. The genetic factors associated with Wnt signaling pathway in colorectal cancer. Life Sci. 2020, 256, 118006. [Google Scholar] [CrossRef]
- Houdkova, M.; Rondevaldova, J.; Doskocil, I.; Kokoska, L. Evaluation of antibacterial potential and toxicity of plant volatile compounds using new broth microdilution volatilization method and modified MTT assay. Fitoterapia 2017, 118, 56–62. [Google Scholar] [CrossRef] [PubMed]
- Flieger, J.; Franus, W.; Panek, R.; Szymańska-Chargot, M.; Flieger, W.; Flieger, M.; Kołodziej, P. Green synthesis of silver nanoparticles using natural extracts with proven antioxidant activity. Molecules 2021, 26, 4986. [Google Scholar] [CrossRef] [PubMed]

Disclaimer/Publisher’s Note: The statements, opinions and data contained in all publications are solely those of the individual author(s) and contributor(s) and not of MDPI and/or the editor(s). MDPI and/or the editor(s) disclaim responsibility for any injury to people or property resulting from any ideas, methods, instructions or products referred to in the content. |
© 2024 by the authors. Licensee MDPI, Basel, Switzerland. This article is an open access article distributed under the terms and conditions of the Creative Commons Attribution (CC BY) license (https://creativecommons.org/licenses/by/4.0/).
Share and Cite
Wang, D.; Ke, H.; Wang, H.; Shen, J.; Jin, Y.; Lu, B.; Wang, B.; Li, S.; Li, Y.; Im, W.T.; et al. Green Synthesis of Silver Nanoparticles (CM-AgNPs) from the Root of Chuanminshen for Improving the Cytotoxicity Effect in Cancer Cells with Antibacterial and Antioxidant Activities. Molecules 2024, 29, 5682. https://doi.org/10.3390/molecules29235682
Wang D, Ke H, Wang H, Shen J, Jin Y, Lu B, Wang B, Li S, Li Y, Im WT, et al. Green Synthesis of Silver Nanoparticles (CM-AgNPs) from the Root of Chuanminshen for Improving the Cytotoxicity Effect in Cancer Cells with Antibacterial and Antioxidant Activities. Molecules. 2024; 29(23):5682. https://doi.org/10.3390/molecules29235682
Chicago/Turabian StyleWang, Dandan, Haijing Ke, Hongtao Wang, Jingyu Shen, Yan Jin, Bo Lu, Bingju Wang, Shuang Li, Yao Li, Wan Taek Im, and et al. 2024. "Green Synthesis of Silver Nanoparticles (CM-AgNPs) from the Root of Chuanminshen for Improving the Cytotoxicity Effect in Cancer Cells with Antibacterial and Antioxidant Activities" Molecules 29, no. 23: 5682. https://doi.org/10.3390/molecules29235682
APA StyleWang, D., Ke, H., Wang, H., Shen, J., Jin, Y., Lu, B., Wang, B., Li, S., Li, Y., Im, W. T., Siddiqi, M. Z., & Zhu, H. (2024). Green Synthesis of Silver Nanoparticles (CM-AgNPs) from the Root of Chuanminshen for Improving the Cytotoxicity Effect in Cancer Cells with Antibacterial and Antioxidant Activities. Molecules, 29(23), 5682. https://doi.org/10.3390/molecules29235682

